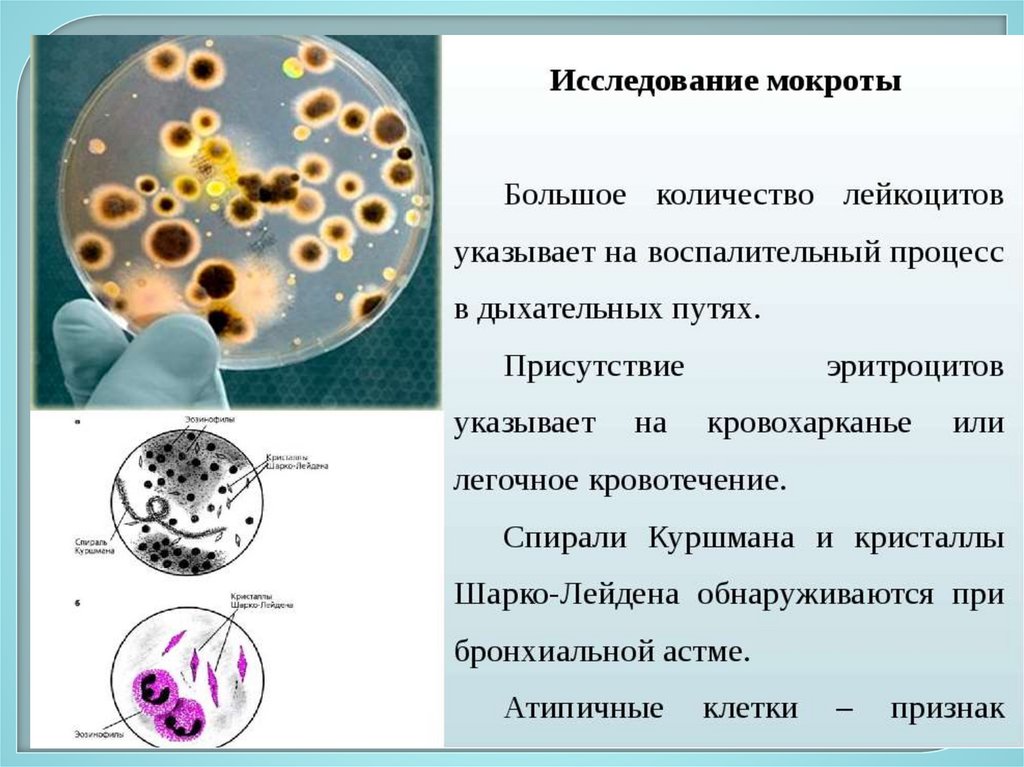

Похожие презентации:
Сестринский процесс при заболеваниях органов дыхания
1. Сестринский процесс при заболеваниях органов дыхания
КГБПОУ «Дивногорский медицинский техникум»Лекция №3
преподаватель высшей квалификационной категории
Т.А.Снытко
2.
3.
4.
5.
6. СЕСТРИНСКОЕ ОБСЛЕДОВАНИЕ ПАЦИЕНТОВ С ЗАБОЛЕВАНИЯМИ ОРГАНОВ ДЫХАНИЯ
1.Расспрос
7. Жалобы
ОдышкаКашель
Выделение мокроты
Кровохарканье
Приступы удушья
Боль в грудной клетке
Нередко наблюдаются также общие симптомы:
повышение температуры тела,
озноб,
слабость,
недомогание,
потливость.
8. Субъективное обследование Жалобы
1. КашельНепродуктивный (сухой) - без выделения
мокроты.
Продуктивный (влажный) - с выделением
мокроты.
9.
10. Субъективное обследование Жалобы
2. МокротаХарактер мокроты:
Слизистая - вязкая, прозрачная, бесцветная
или белесоватая (пневмония, острый бронхит).
Слизисто-гнойная - вязкая, серо-желтая
(хронический бронхит, пневмония).
Гнойная - желтоватая или зеленоватая, с
неприятным «гнойным» запахом (абсцесс
лёгкого, бронхоэктатическая болезнь)
Серозная - жидкая, прозрачная (застой в
малом круге кровообращения – сердечная
астма, отек легких).
11. Субъективное обследование Жалобы
Кровянистая (геморрагическая) – кровохарканье.Может быть:
1. Ржавого цвета (крупозная пневмония).
2. С прожилками или сгустками крови (рак легкого,
туберкулез, абсцесс легкого, бронхоэктатическая
болезнь).
3. Вид «малинового желе» (рак лёгкого).
12.
13.
14. Субъективное обследование Жалобы
4. Удушье - сильная, граничащая с асфиксиейодышка, возникающая внезапно в виде приступа.
Может быть инспираторного, экспираторного
и смешанного типа.
Развивается при бронхиальной астме,
сердечной астме, отеке легких, тромбэмболии
легочной артерии, отеке гортани, инородном
теле в верхних дыхательных путях.
15. Субъективное обследование Жалобы
5. Боль в грудной клеткеЧаще возникает при поражении плевры
(плеврит, крупозная пневмония, пневмоторакс,
метастазы в плевру).
Боль усиливается при вдохе, кашле, при
наклоне тела в здоровую сторону.
Боль в грудной клетке могут быть другого
происхождения: при миозите, переломе ребер,
невралгии, неврите.
16. Субъективное обследование Жалобы
6. Легочное кровотечениеКровь алого цвета, пенистая, с пузырьками
воздуха. Может быть при туберкулезе, раке
легкого, бронхоэктазах, абсцессе легкого.
7. Общие жалобы (связаны с
интоксикацией): повышение температуры,
головная боль, бессонница, снижение аппетита,
общая слабость, потливость, снижение
трудоспособности.
17. Субъективное обследование Анамнез болезни
Следует выяснить:начало болезни (внезапно или постепенно,
первоначальные проявления),
причину заболевания по мнению больного
(простуда, реакция на запахи, изменение
метеоусловий и т.д.),
характер течения болезни (частота
обострений, появление осложнений и др.),
проводимое обследование, лечение и его
эффективность.
18. Субъективное обследование Анамнез жизни
Выяснить:перенесенные болезни органов дыхания,
травмы грудной клетки,
вредные привычки (курение),
аллергоанамнез,
особенности профессиональных и
производственных вредностей
(запыленность, загазованность рабочего
места, резкие перепады температуры
воздуха и т.д.).
19. Объективное обследование Осмотр
1. Положение в постели (активное, пассивное,вынужденное)
Вынужденное положение:
сидя, опираясь на руки – при приступе
бронхиальной астмы;
лежа на одном боку – при боли в
грудной клетке при
поражении плевры;
с приподнятой верхней половиной
туловища – при одышке.
20. Объективное обследование Осмотр
2. Кожные покровы: цианоз, бледность илигиперемия.
3. Осмотр рук: пальцы в виде «барабанных
палочек» и ногти в виде «часовых стекол» (при
хронических нагноительных заболеваниях
легких )
21. Форма грудной клетки
Нормальные формы груднойклетки:
-нормостеническая,
-гиперстеническая,
- астеническая)
22.
Типы конституции(классификация М.В.Черноруцкого)
Астенический
Нормостенический
Гиперстенический
23. Объективное обследование Осмотр
4. Осмотр грудной клетки:- патологическая форма
Эмфизематозная грудная клетка - расширенная,
бочкообразная, приподнята как в положении максимального
вдоха (при бронхиальной астме, при эмфиземе легких).
Паралитическая грудная клетка - резко удлинена, опущена как
при положении максимального выдоха (при туберкулезе легких,
раке легкого, у резко исхудавших лиц астенического
телосложения).
Килевидная грудная клетка («куриная грудь) - резко
выдающаяся вперед грудина (врожденная патология, рахит).
Воронкообразная грудная клетка («грудь сапожника») –
воронокобразное вдавление в грудине (врожденная патология,
рахит).
24. Объективное обследование Осмотр
25. Объективное обследование Осмотр
- искривление позвоночника:вбок (сколиоз), назад (кифоз), вперед (лордоз),
сочетанные искривления в сторону и сзади
(кифосколиоз).
26. Объективное обследование Осмотр
- односторонняя деформация грудной клетки:увеличение в размерах одной половины грудной
клетки (гидроторакс, пневмоторакс).
уменьшение в размерах одной
половины грудной клетки (удаление
части легкого, ателектаз).
- участие обеих половин грудной клетки
в акте дыхания.
Отставание одной из половин может наблюдаться при
крупозной пневмонии, абсцессе легкого, плевритах.
27. Объективное обследование Осмотр
5. Определение типа дыханияГрудной тип дыхания: за счет сокращения
межреберных мышц (чаще у женщин).
Брюшной тип дыхания: за счет сокращения
диафрагмы (чаще у мужчин).
Смешанный тип дыхания:
дыхательные движения за
счет сокращения межреберных
мышц и диафрагмы
(у лиц пожилого возраста).
28. Объективное обследование Осмотр
6. Подсчет частоты дыханияНормой для взрослого человека в покое являются
16—20 дыхательных движений в 1 минуту.
Учащение частоты дыхания (тахипноэ): в норме
при физической и нервной нагрузке, а также при
лихорадке, при большинстве заболеваний органов
дыхания.
Урежение дыхания (брадипноэ): в норме во сне, а
также при сужении гортани или трахеи, во время
приступа бронхиальной астмы.
29. Объективное обследование Осмотр
7. Определение ритма дыханияВ норме дыхание ритмичное.
При расстройствах функции дыхательного центра
(отравление, травмы и опухоли головного мозга,
инсульт) дыхание становится периодическим.
Варианты периодического дыхания:
дыхание Чейн - Стокса
дыхание Биота
дыхание Куссмауля
30. Объективное обследование Пальпация грудной клетки
Выявления локализации болезненныхучастков при патологии ребер.
Голосовое дрожание.
Эластичность грудной клетки.
31. Виды перкуссии
Сравнительная перкуссияДает возможность определить
изменения на симметричных участках в
легких, плевральной и брюшной
полости.
Топографическая перкуссия
Позволяет определить границы и
размеры органов, а также очагов
поражения
32. Объективное обследование Перкуссия легких
Ясный (лёгочный) звук – над легкими внорме.
Тимпанический звук – над участком
лёгкого с абсцессом.
Коробочный звук - при эмфиземе,
приступе бронхиальной астмы.
Притуплённый звук – при пневмонии;
ателектазе, опухоли легкого.
Тупой звук – экссудативный плеврит,
гидроторакс, пневмоторакс.
33.
Сравнительная перкуссия легкихСравнительная перкуссия легких проводится
методом громкой перкуссии
34. Аускультация легких
35. Последовательность выслушивания легких
36. Объективное обследование Аускультация легких
1. Виды дыхания:везикулярное дыхание – в норме над
легкими;
ослабленное везикулярное дыхание –
в норме при чрезмерном развитии мышц и
ПЖК,
при патологии – эмфизема, пневмония;
усиленное везикулярное дыхание –
в норме при слабом развитии мышц и ПЖК, в
детском возрасте (пуэрильное дыхание),
при патологии – жесткое дыхание (усилен
вдох и выдох) при бронхите;
37. Объективное обследование Аускультация легких
бронхиальное дыхание(ларинготрахеальное)
в норме над гортанью и трахеей,
при патологии при крупозной пневмонии,
небольшом абсцессе;
амфорическое дыхание – над большой
полостью при абсцессе или каверне.
38. Объективное обследование Аускультация легких
2. Побочные дыхательные шумы:влажные хрипы – при скоплении жидкой
мокроты.
Могут быть мелкопузырчатые,
среднепузырчатые и крупнонузырчатые
влажные хрипы в зависимости от размера
бронхов;
сухие хрипы –при вязкой мокроте или при
сужении бронхов.
Могут быть свистящими (в мелких бронхах) и
жужжащими (в средних и крупных бронхах);
39. Объективное обследование Аускультация легких
шум трения плевры – при трении друг одруга листков плевры при плеврите;
крепитация – звук разлипания альвеол
(при крупозной пневмонии).
40.
41.
42.
43.
44.
45. Дополнительное обследование
Инструментальные методы:1. Рентгенологические методы –
рентгенография грудной клетки,
флюорография, бронхография,
компьютерная томография
46. Дополнительное обследование
2. Бронхоскопия3. Функциональная диагностика системы
внешнего дыхания:
Спирометрия, спирография
Пневмотахометрия (метод измерения
«пиковых» скоростей воздушного потока
при форсированных вдохе и выдохе)
47.
СПАСИБО ЗА ВНИМАНИЕ!48. Задача
В поликлинику на прием обратился пациент 60 лет по поводуобострения хронического бронхита.
Предъявляет жалобы на кашель с отделением вязкой слизистогнойной мокроты. Пациента беспокоит неприятный запах мокроты,
от которого он старается избавиться с помощью ароматизированной
жевательной резинки. Из-за кашля, усиливающегося ночью, плохо
спит, поэтому на ночь по совету друзей решил принимать либексин.
Для улучшения отхождения мокроты выкуривает натощак сигарету.
Частота дыхания 24 в минуту, пульс 84 в минуту
удовлетворительного наполнения, АД 130/80 мм рт. ст.
Задания
1. Определите проблемы пациента; сформулируйте цели и
составьте план сестринского ухода.
2. Обучите пациента методике постурального дренажа.
49. Задача
Вы посещаете на дому пациента с диагнозом«Рак легкого».
Во время кашля у него внезапно стала
выделяться в большом количестве алая кровь с
примесью пузырьков воздуха.
Объективно: пациент бледен, пульс частый,
слабый, 110 ударов в минуту, АД – 95/65 мм рт.ст.
Задание:
1. Определите и обоснуйте неотложное
состояние пациента.
2. Составьте алгоритм оказания неотложной
помощи.
50. Задача
Вас позвала соседка из-за ухудшениясамочувствия ее 20-летнего сына, получающего
лечение дома по поводу пневмонии.
Молодой человек жалуется на чувство жара,
сильную головную боль, слабость, плохой сон. Он
почти ничего не ест, мало пьет. На вопросы
отвечает с трудом из-за спутанного сознания и
заторможенности. Температура тела до 39,9°С
Задание:
1. Определите и обоснуйте неотложное
состояние пациента.
2. Составьте алгоритм оказания неотложной
помощи.
51. Задача
У женщины, которая пришла в гости кзнакомым, развился приступ экспираторного
удушья.
В
анамнезе
–
атопическая
бронхиальная астма в течение 5 лет, аллергия
на шерсть кошки.
Знакомые позвали медицинскую сестру
из соседней квартиры.
Задание:
1. Определите и обоснуйте неотложное
состояние пациентки.
2.
Составьте
алгоритм
оказания
неотложной помощи.

Медицина
Медицина








